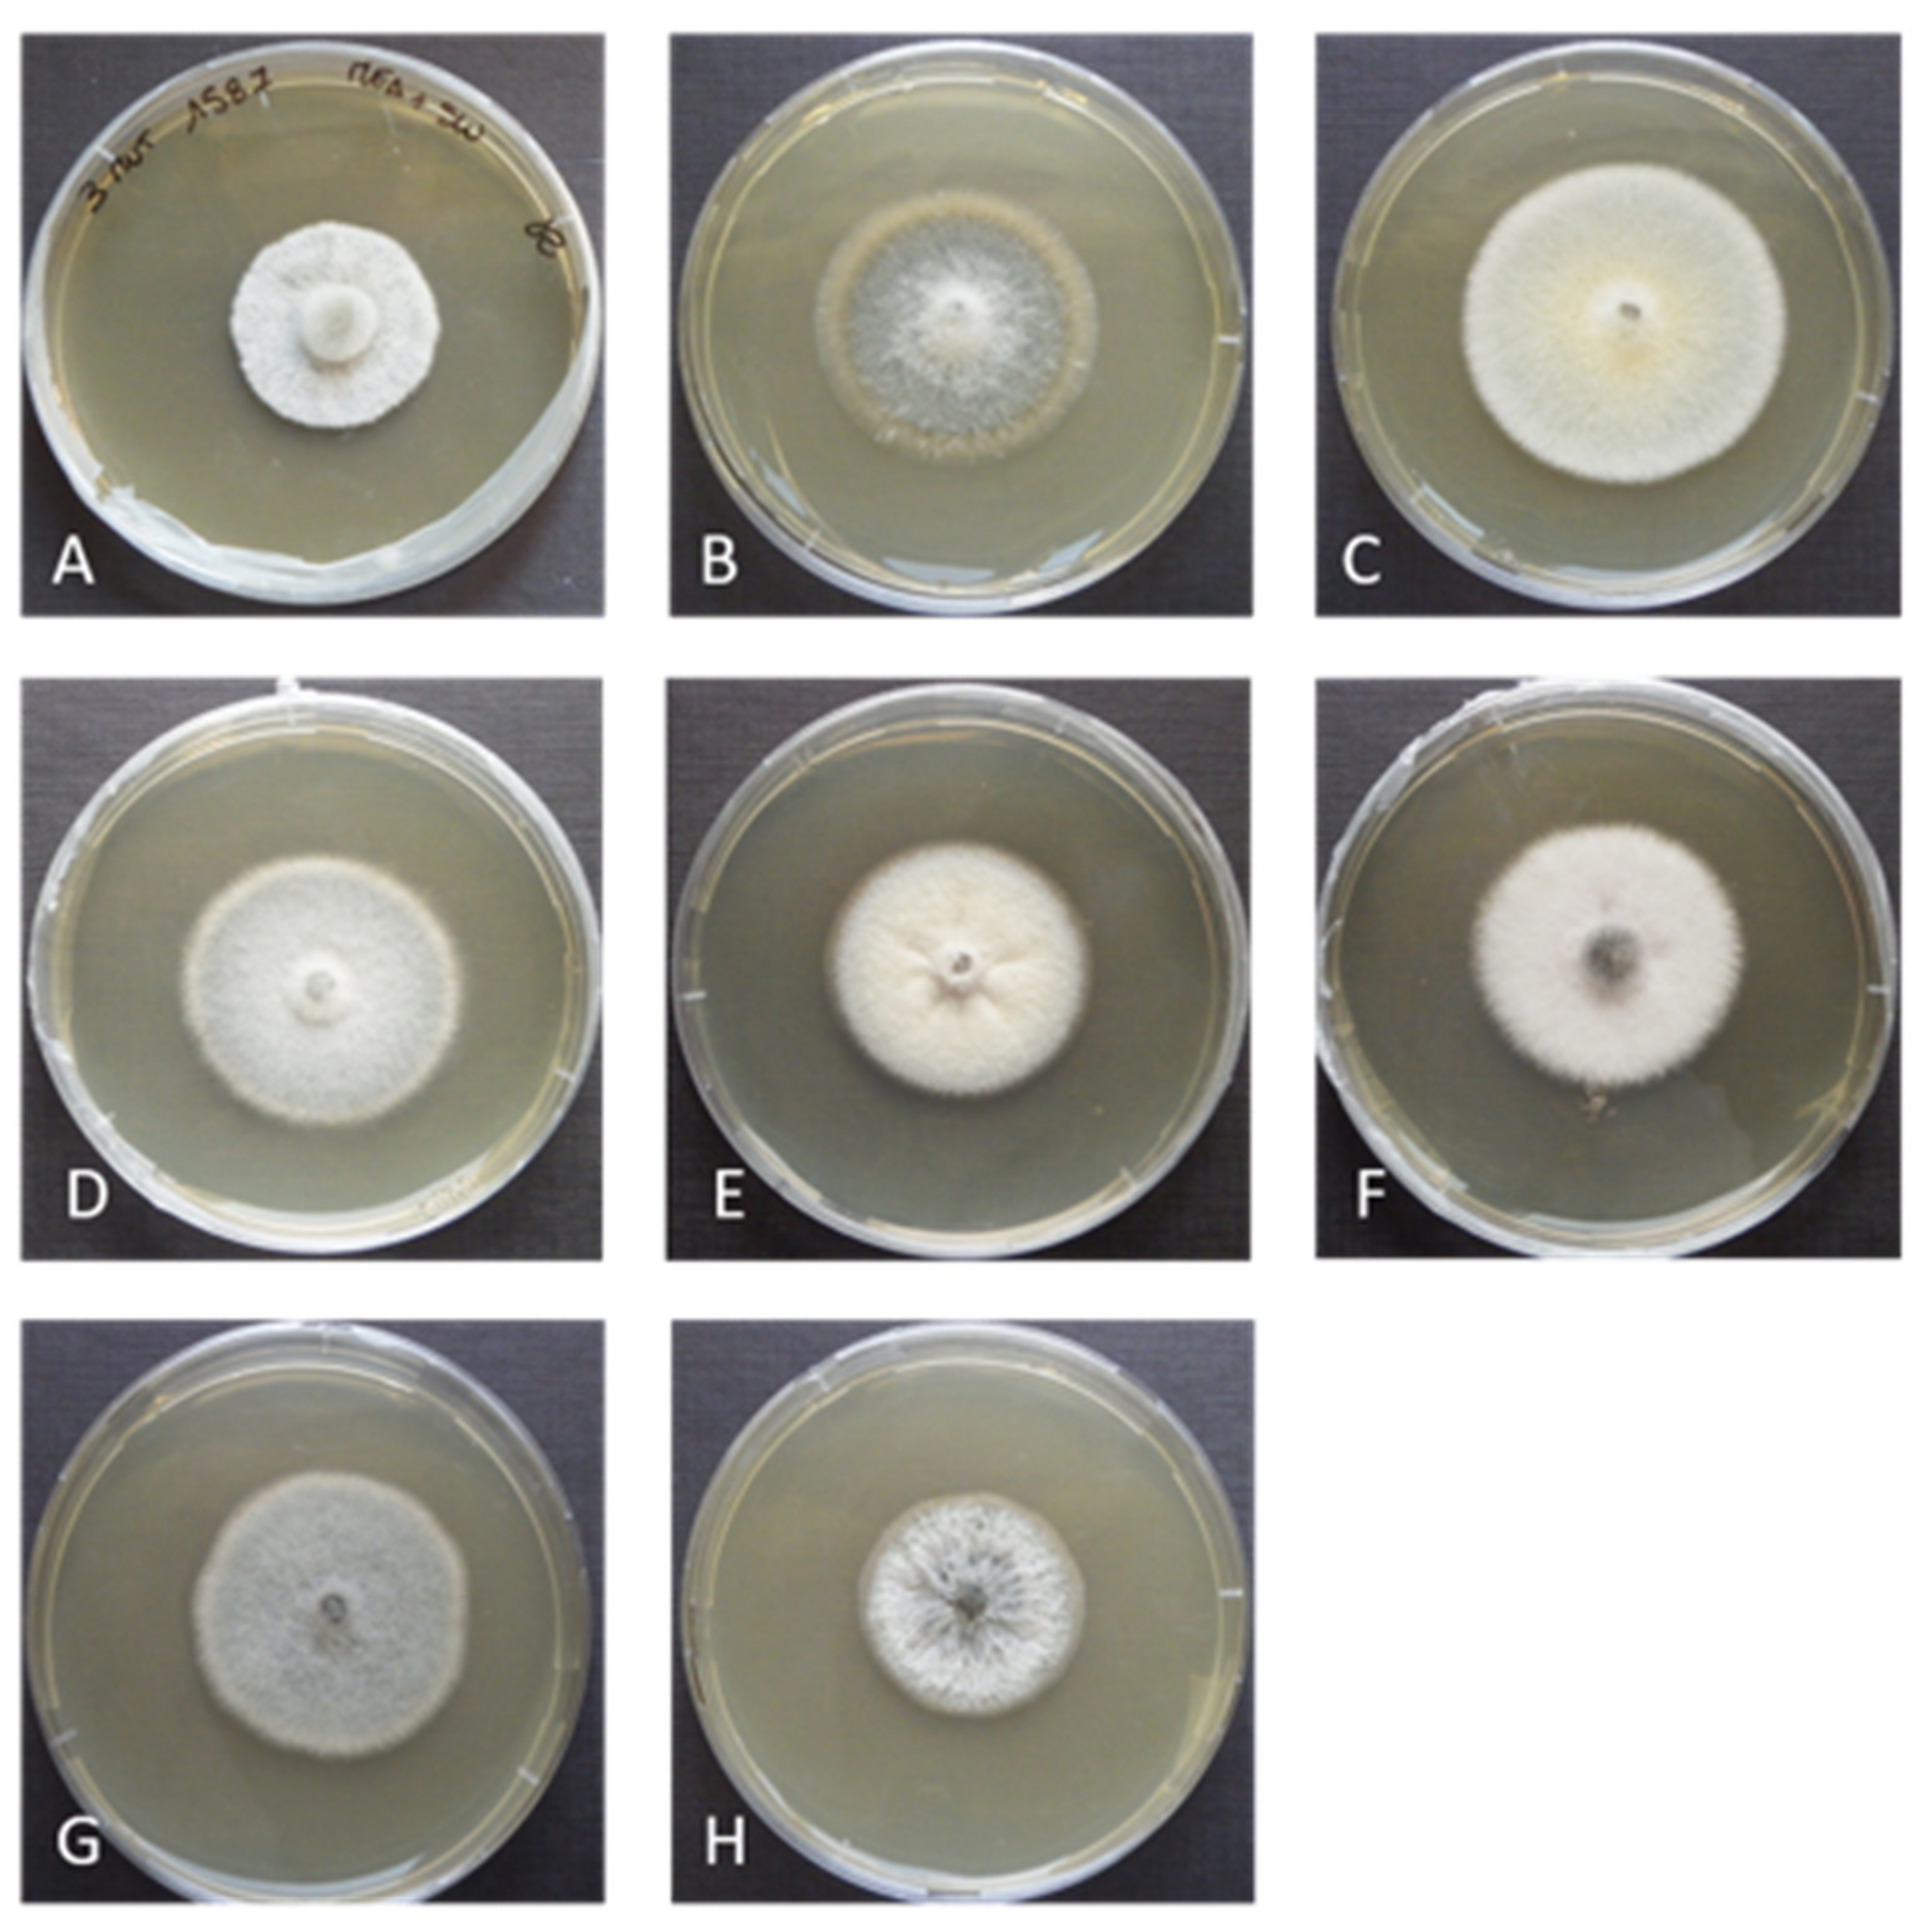
Applsci 11 05452 g005 Applsci 11 05452 g005
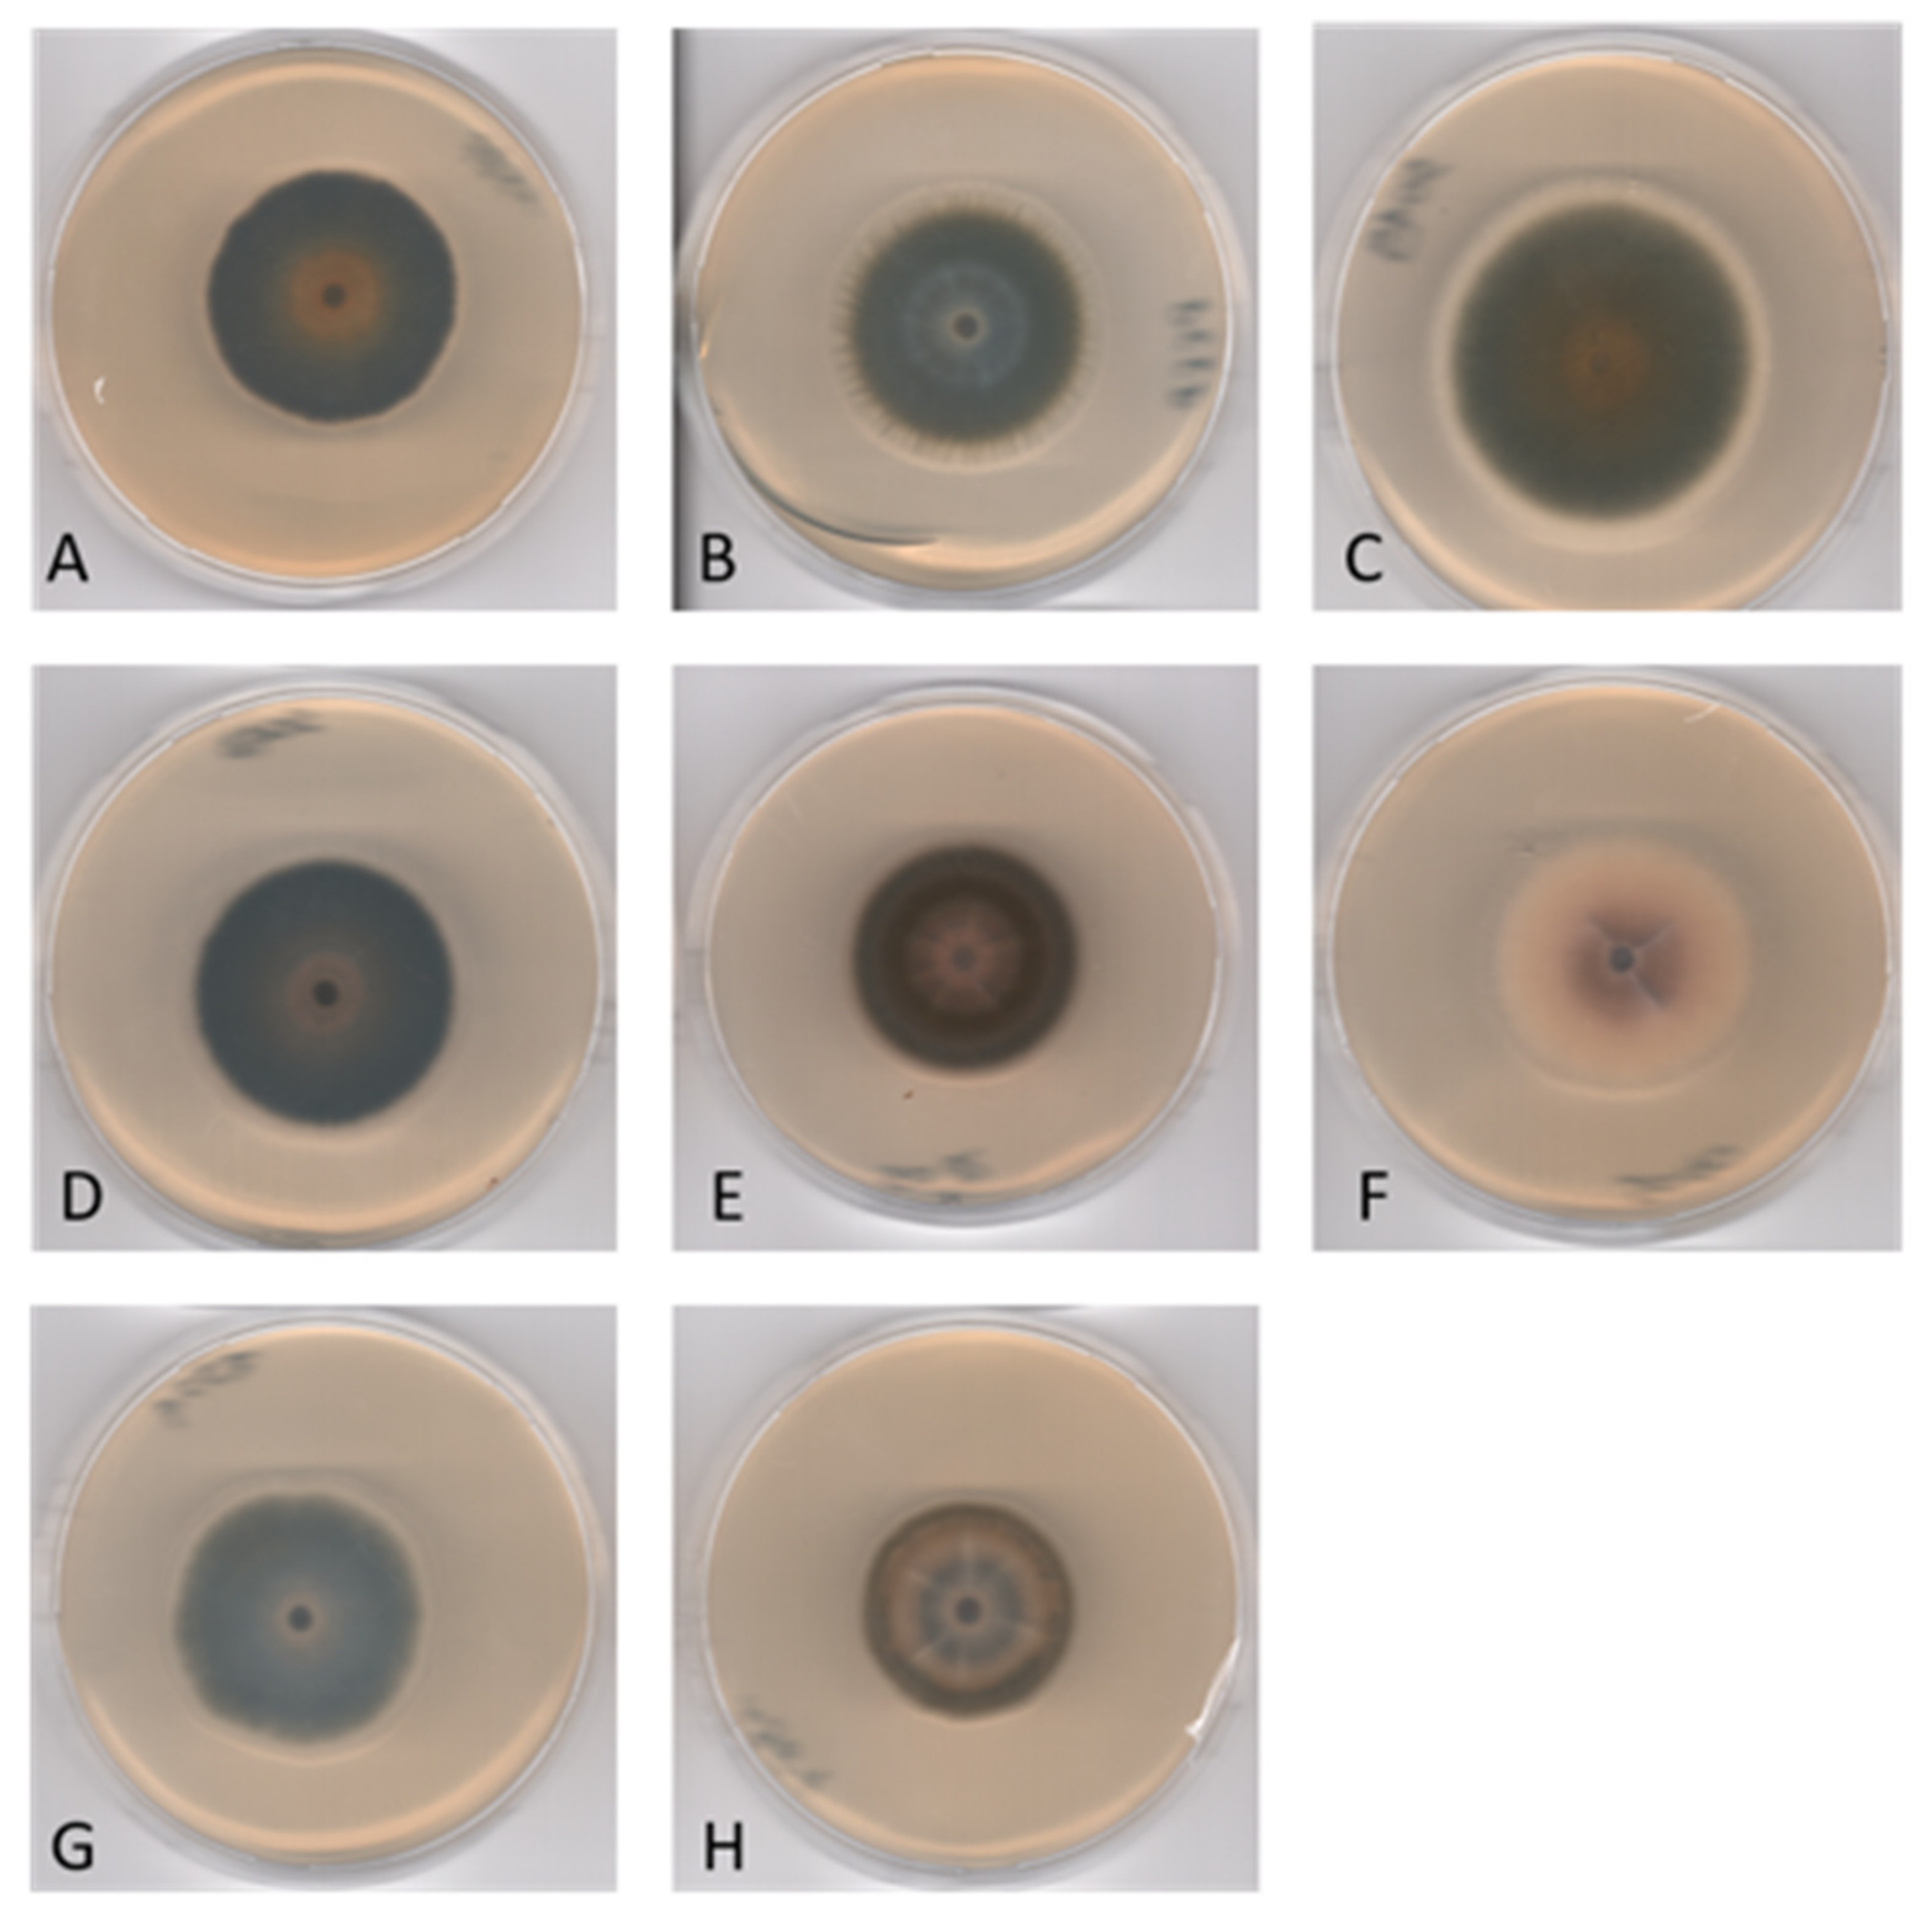
Applsci 11 05452 g006 Applsci 11 05452 g006

Corollospora mediterranea: A Novel Species Complex in the Mediterranean Sea
Abstract
1. Introduction
2. Materials and Methods
2.1. Fungal Isolates
2.2. Morphological Analysis
2.3. DNA Extraction, PCR Amplification, and Data Assembling
2.4. Sequence Alignment and Phylogenetic Analysis
3. Results
3.1. Phylogenetic Inference
3.2. Taxonomy
4. Discussion
5. Conclusions
Author Contributions
Funding
Institutional Review Board Statement
Informed Consent Statement
Data Availability Statement
Acknowledgments
Conflicts of Interest
References
- Jones, E.B.G.; Pang, K.-L.; Abdel-Wahab, M.A.; Scholz, B.; Hyde, K.D.; Boekhout, T.; Ebel, R.; Rateb, M.E.; Henderson, L.; Sakayaroj, J.; et al. An online resource for marine fungi. Fungal Divers. 2019, 96, 347–433. [Google Scholar] [CrossRef]
- Jones, E.G.; Ju, W.-T.; Lu, C.-L.; Guo, S.-Y.; Pang, K.-L. The halosphaeriaceae revisited. Bot. Mar. 2017, 60, 453–468. [Google Scholar] [CrossRef]
- Abdel-Wahab, M.A.; Nagahama, T.; Abdel-Aziz, F.A. Two new Corollospora species and one new anamorph based on morphological and molecular data. Mycoscience 2009, 50, 147–155. [Google Scholar] [CrossRef]
- Hsieh, S.Y.; Moss, S.T.; Jones, E.B.G. Ascoma development in the marine ascomycete Corollospora gracilis (Halosphaeriales, Hypocreomycetidae, Sordariomycetes). Bot. Mar. 2007, 50, 302–313. [Google Scholar] [CrossRef]
- Walker, A.K.; Robicheau, B.M. Fungal diversity and community structure from coastal and barrier island beaches in the United States Gulf of Mexico. Sci. Rep. 2021, 11, 3889. [Google Scholar] [CrossRef] [PubMed]
- Velez, P.; Gasca-Pineda, J.; Nakagiri, A.; Hanlin, R.T.; Gonzalez, M.C. Genetic diversity and population structure of Corollospora maritima sensu lato: New insights from population genetics. Bot. Mar. 2016, 59, 307–320. [Google Scholar] [CrossRef]
- Raghukumar, S. Fungi in Coastal and Oceanic Marine Ecosystems: Marine Fungi; Springer: Cham, Switzerland, 2017. [Google Scholar]
- Overy, D.P.; Bayman, P.; Kerr, R.G.; Bills, G.F. An assessment of natural product discovery from marine (sensu strictu) and marine-derived fungi. Mycology 2014, 5, 145–167. [Google Scholar] [CrossRef]
- Overy, D.P.; Rama, T.; Oosterhuis, R.; Walker, A.K.; Pang, K.L. The Neglected Marine Fungi, Sensu stricto, and Their Isolation for Natural Products’ Discovery. Mar. Drugs 2019, 17, 42. [Google Scholar] [CrossRef]
- Kirk, P.W.; Gordon, A.S. Hydrocarbon degradation by fiilamentous marine higher fungi. Mycologia 1988, 80, 776–782. [Google Scholar] [CrossRef]
- Liberra, K.; Jansen, R.; Lindequist, U. Corollosporine, a new phthalide derivative from the marine fungus Corollospora maritima Werderm. 1069. Pharmazie 1998, 53, 578–581. [Google Scholar] [CrossRef]
- Furuya, K.; Okudaira, M.; Shindo, T.; Sato, A. Corollospora pulchella, a marine fungus producing antibiotics, melinacidins III, IV and gancidin W. Annu. Rep. Sankyo Res. Lab. 1985, 37, 140–142. [Google Scholar]
- Alvi, K.A.; Casey, A.; Nair, B.G. Pulchellalactam: A CD45 protein tyrosine phosphatase inhibitor from the marine fungus Corollospora pulchella. J. Antibiot. 1998, 51, 515–517. [Google Scholar] [CrossRef]
- MacKenzie, S.E.; Gurusamy, G.S.; Piorko, A.; Strongman, D.B.; Hu, T.M.; Wright, J.L.C. Isolation of sterols from the marine fungus Corollospora lacera. Can. J. Microbiol. 2004, 50, 1069–1072. [Google Scholar] [CrossRef] [PubMed]
- Campbell, J.; Shearer, C.A.; Mitchell, J.I.; Eaton, R.A. Corollospora revisited: A molecular approach. In Fungi in Marine Environment; Hyde, K.D., Ed.; (Fungal Diversity Research Series); Fungal Diversity Press: Hong Kong, China, 2002; Volume 7, pp. 15–33. [Google Scholar]
- Jones, E.G.; Johnson, R.; Moss, S. Taxonomic studies of the Halosphaeriaceae: Corollospora Werdermann. Bot. J. Linn. Soc. 1983, 87, 193–212. [Google Scholar] [CrossRef]
- Lutley, M.; Wilson, I.M. Development and fine structure of ascospores in the marine fungus Ceriosporopsis halima. Trans. Br. Mycol. Soc. 1972, 58, 393–402. [Google Scholar] [CrossRef]
- Lutley, M.; Wilson, I.M. Observations on the fine structure of ascospores of marine fungi: Halosphaeria appendiculata, Torpedospora radiata and Corollospora maritima. Trans. Br. Mycol. Soc. 1972, 59, 219–227. [Google Scholar] [CrossRef]
- Jones, E.B.G.; Sakayaroj, J.; Suetrong, S.; Somrithipol, S.; Pang, K.L. Classification of marine Ascomycota, anamorphic taxa and Basidiomycota. Fungal Divers. 2009, 35, 187. [Google Scholar]
- Koch, J. Some Lignicolous Marine Fungi From Thailand, including 2 New Species. Nord. J. Bot. 1986, 6, 497–499. [Google Scholar] [CrossRef]
- Kohlmeyer, J.; Volkmannkohlmeyer, B. Corollospora armoricana sp. nov An Arenicolous Ascomycete from Brittany (France). Can. J. Bot. Rev. Can. Bot. 1989, 67, 1281–1284. [Google Scholar] [CrossRef]
- McKeown, T.A.; Moss, S.T.; Jones, E.B.G. Ultrastructure of the melanized ascospores of Corollospora fusca. Can. J. Bot. Rev. Can. Bot. 1996, 74, 60–66. [Google Scholar] [CrossRef]
- Jones, E.B.G. Fifty years of marine mycology. Fungal Divers. 2011, 50, 73–112. [Google Scholar] [CrossRef]
- Sundari, R.; Vikineswary, S.; Yusoff, M.; Jones, E.B.G. Corollospora besarispora, a new arenicolous marine fungus from Malaysia. Mycol. Res. 1996, 100, 1259–1262. [Google Scholar] [CrossRef]
- Schoch, C.L.; Crous, P.W.; Groenewald, J.Z.; Boehm, E.W.A.; Burgess, T.I.; de Gruyter, J.; de Hoog, G.S.; Dixon, L.J.; Grube, M.; Gueidan, C.; et al. A class-wide phylogenetic assessment of Dothideomycetes. Stud. Mycol. 2009, 64, 1–15. [Google Scholar] [CrossRef]
- Schoch, C.L.; Seifert, K.A.; Huhndorf, S.; Robert, V.; Spouge, J.L.; Levesque, C.A.; Chen, W.; Bolchacova, E.; Voigt, K.; Crous, P.W.; et al. Nuclear ribosomal internal transcribed spacer (ITS) region as a universal DNA barcode marker for Fungi. Proc. Natl. Acad. Sci. USA 2012, 109, 6241–6246. [Google Scholar] [CrossRef] [PubMed]
- Panno, L.; Bruno, M.; Voyron, S.; Anastasi, A.; Gnavi, G.; Miserere, L.; Varese, G.C. Diversity, ecological role and potential biotechnological applications of marine fungi associated to the seagrass Posidonia oceanica. New Biotechnol. 2013, 30, 685–694. [Google Scholar] [CrossRef] [PubMed]
- Bovio, E.; Gnavi, G.; Prigione, V.; Spina, F.; Denaro, R.; Yakimov, M.; Calogero, R.; Crisafi, F.; Varese, G.C. The culturable mycobiota of a Mediterranean marine site after an oil spill: Isolation, identification and potential application in bioremediation. Sci. Total Environ. 2017, 576, 310–318. [Google Scholar] [CrossRef] [PubMed]
- Garzoli, L.; Gnavi, G.; Tamma, F.; Tosi, S.; Varese, G.C.; Picco, A.M. Sink or swim: Updated knowledge on marine fungi associated with wood substrates in the Mediterranean Sea and hints about their potential to remediate hydrocarbons. Prog. Oceanogr. 2015, 137, 140–148. [Google Scholar] [CrossRef]
- Abdel-Wahab, M.A.; Hodhod, M.S.; Bahkali, A.H.A.; Jones, E.B.G. Marine fungi of Saudi Arabia. Bot. Mar. 2014, 57, 323–335. [Google Scholar] [CrossRef]
- Dayarathne, M.C.; Wanasinghe, D.N.; Devadatha, B.; Abeywickrama, P.; Jones, E.B.G.; Chomnunti, P.; Sarma, V.V.; Hyde, K.D.; Lumyong, S.; McKenzie, E.H.C. Modern taxonomic approaches to identifying diatrypaceous fungi from marine habitats, with a novel genus Halocryptovalsa Dayarathne & KDHyde, gen. nov. Cryptogam. Mycol. 2020, 41, 21–67. [Google Scholar] [CrossRef]
- Jones, E.G.; Pang, K.-L. (Eds.) Marine Fungi and Fungal-Like Organisms; Walter de Gruyter: Berlin, Germany, 2012. [Google Scholar]
- Poli, A.; Bovio, E.; Ranieri, L.; Varese, G.C.; Prigione, V. News from the Sea: A New Genus and Seven New Species in the Pleosporalean Families Roussoellaceae and Thyridariaceae. Diversity 2020, 12, 144. [Google Scholar] [CrossRef]
- Panebianco, C.; Tam, W.Y.; Jones, E.B.G. The effect of pre-inoculation of balsa wood by selected marine fungi and their effect on subsequent colonisation in the sea. Fungal Divers. 2002, 10, 77–88. [Google Scholar]
- White, T.J.; Bruns, T.; Lee, S.; Taylor, J. Amplification and direct sequencing of fungal ribosomal RNA genes for phylogenetics. PCR Protoc. Guide Methods Appl. 1990, 18, 315–322. [Google Scholar]
- Vilgalys, R.; Hester, M. Rapid genetic identification and mapping of enzymatically amplified ribosomal DNA from several Cryptococcus species. J. Bacteriol. 1990, 172, 4238–4246. [Google Scholar] [CrossRef] [PubMed]
- Matheny, P.B.; Wang, Z.; Binder, M.; Curtis, J.M.; Lim, Y.W.; Nilsson, R.H.; Hughes, K.W.; Hofstetter, V.; Ammirati, J.F.; Schoch, C.L.; et al. Contributions of rpb2 and tef1 to the phylogeny of mushrooms and allies (Basidiomycota, Fungi). Mol. Phylogenetics Evol. 2007, 43, 430–451. [Google Scholar] [CrossRef]
- Glass, N.L.; Donaldson, G.C. Development of primer sets designed for use with the PCR to amplify conserved genes from filamentous ascomycetes. Appl. Environ. Microbiol. 1995, 61, 1323–1330. [Google Scholar] [CrossRef]
- Raja, H.A.; Baker, T.R.; Little, J.G.; Oberlies, N.H. DNA barcoding for identification of consumer-relevant mushrooms: A partial solution for product certification? Food Chem. 2017, 214, 383–392. [Google Scholar] [CrossRef]
- Liu, Y.J.; Whelen, S.; Hall, B.D. Phylogenetic relationships among ascomycetes: Evidence from an RNA polymerse II subunit. Mol. Biol. Evol. 1999, 16, 1799–1808. [Google Scholar] [CrossRef]
- Sakayaroj, J.; Pang, K.L.; Jones, E.B.G. Multi-gene phylogeny of the Halosphaeriaceae: Its ordinal status, relationships between genera and morphological character evolution. Fungal Divers. 2011, 46, 87–109. [Google Scholar] [CrossRef]
- Vaidya, G.; Lohman, D.J.; Meier, R. SequenceMatrix: Concatenation software for the fast assembly of multi-gene datasets with character set and codon information. Cladistics 2011, 27, 171–180. [Google Scholar] [CrossRef]
- Darriba, D.; Taboada, G.L.; Doallo, R.; Posada, D. jModelTest 2: More models, new heuristics and parallel computing. Nat. Methods 2012, 9, 772. [Google Scholar] [CrossRef] [PubMed]
- Stamatakis, A. RAxML version 8: A tool for phylogenetic analysis and post-analysis of large phylogenies. Bioinformatics 2014, 30, 1312–1313. [Google Scholar] [CrossRef]
- Ronquist, F.; Teslenko, M.; van der Mark, P.; Ayres, D.L.; Darling, A.; Hohna, S.; Larget, B.; Liu, L.; Suchard, M.A.; Huelsenbeck, J.P. MrBayes 3.2: Efficient Bayesian Phylogenetic Inference and Model Choice Across a Large Model Space. Syst. Biol. 2012, 61, 539–542. [Google Scholar] [CrossRef]
- Gnavi, G.; Garzoli, L.; Polil, A.; Prigione, V.; Burgaud, G.; Varese, G.C. The culturable mycobiota of Flabellia petiolata: First survey of marine fungi associated to a Mediterranean green alga. PLoS ONE 2017, 12. [Google Scholar] [CrossRef] [PubMed]
- Garzoli, L.; Poli, A.; Prigione, V.; Gnavi, G.; Varese, G.C. Peacock’s tail with a fungal cocktail: First assessment of the mycobiota associated with the brown alga Padina pavonica. Fungal Ecol. 2018, 35, 87–97. [Google Scholar] [CrossRef]
- Poli, A.; Vizzini, A.; Prigione, V.; Varese, G.C. Basidiomycota isolated from the Mediterranean Sea—Phylogeny and putative ecological roles. Fungal Ecol. 2018, 36, 51–62. [Google Scholar] [CrossRef]
- Jeewon, R.; Hyde, K.D. Establishing species boundaries and new taxa among fungi: Recommendations to resolve taxonomic ambiguities. Mycosphere 2016, 7, 1669–1677. [Google Scholar] [CrossRef]
- Kistler, H.C. Genetic diversity in the plant-pathogenic fungus Fusarium oxysporum. Phytopathology 1997, 87, 474–479. [Google Scholar] [CrossRef]
- O’Donnell, K.; Cigelnik, E. Two divergent intragenomic rDNA ITS2 types within a monophyletic lineage of the fungus Fusarium are nonorthologous. Mol. Phylogenetics Evol. 1997, 7, 103–116. [Google Scholar] [CrossRef]
- O’Donnell, K. Molecular phylogeny of the Nectria haematococca-Fusarium solani species complex. Mycologia 2000, 92, 919–938. [Google Scholar] [CrossRef]
- Jancic, S.; Nguyen, H.D.T.; Frisvad, J.C.; Zalar, P.; Schroers, H.J.; Seifert, K.A.; Gunde-Cimerman, N. Taxonomic Revision of the Wallemia sebi Species Complex. PLoS ONE 2015, 10, e0125933. [Google Scholar] [CrossRef]
- Damm, U.; Cannon, P.F.; Woudenberg, J.H.C.; Crous, P.W. The Colletotrichum acutatum species complex. Stud. Mycol. 2012, 73, 37–113. [Google Scholar] [CrossRef] [PubMed]
- Matute, D.R.; Sepulveda, V.E. Fungal species boundaries in the genomics era. Fungal Genet. Biol. 2019, 131, 9. [Google Scholar] [CrossRef] [PubMed]

| Species | Strain | Source | nrITS | nrSSU | nrLSU | TEF-1α | RPB1 | RPB2 | βTUB |
|---|---|---|---|---|---|---|---|---|---|
| Microascales | |||||||||
| Halosphaeriaceae | |||||||||
| Corollospora angusta | NBRC 32102 | Sea foam | JN943383 | JN941667 | JN941478 | -- | JN992397 | -- | -- |
| NBRC 32101 T | Seafoam | JN943381 | JN941668 | JN941477 | -- | -- | -- | -- | |
| C. cinnamomea | NBRC 32125 | Beach sand | AB361023 | JN941666 | JN941479 | -- | JN992396 | -- | -- |
| NBRC 32126 | Beach sand | -- | JN941665 | JN941480 | -- | JN992395 | -- | -- | |
| C. colossa | NBRC 32103 T | Seafoam | -- | JN941664 | JN941481 | -- | JN992394 | -- | -- |
| NBRC 32105 | Seafoam | JN943445 | JN941663 | JN941482 | -- | -- | -- | -- | |
| C. fusca | NBRC 32107 T | Seafoam | JN943382 | JN941662 | JN941483 | -- | JN992393 | -- | -- |
| NBRC 32108 | Seafoam | JN943385 | JN941661 | JN941484 | -- | JN992392 | -- | -- | |
| C. gracilis | NBRC 32110 T | Seafoam | -- | JN941660 | JN941486 | -- | JN992390 | -- | -- |
| NBRC 32111 | Seafoam | JN943386 | JN941659 | JN941487 | -- | JN992389 | -- | -- | |
| C. lacera | NBRC 32121 | Sea foam | -- | JN941658 | JN941488 | -- | JN992388 | -- | -- |
| NBRC 32122 | Seafoam | -- | JN941657 | JN941489 | -- | JN992387 | -- | -- | |
| C. luteola | NBRC 31315 T | Sea foam | -- | JN941656 | JN941490 | -- | -- | -- | -- |
| NBRC 31316 | Sargassum giganteifolium | -- | JN941655 | JN941491 | -- | -- | -- | -- | |
| C. maritima | MUT 1652 | Driftwood | MW543050 * | MW543046 * | MW543054 * | MW577242 * | MW577246 * | MW577250 * | MW556316 * |
| MUT 1662 | Submerged wood | MW543051 * | MW543047 * | MW543055 * | MW577243 * | MW577247 * | MW577251 * | MW556317 * | |
| MUT 3408 | Submerged wood | MW543052 * | MW543048 * | MW543056 * | MW577244 * | MW577248 * | MW577252 * | MW556318 * | |
| MUT 3410 | Submerged wood | MW543053 * | MW543049 * | MW543057 * | MW577245 * | MW577249 * | MW577253 * | MW556319 * | |
| Corollospora mediterranea sp. nov. | MUT 1587 | Driftwood | KF915998 | MW584971 * | MW584962 * | MW703375 * | MW645216 * | MW666025 * | MW727528 * |
| MUT 1938 | Oil-contaminated seawater | MW582548 * | MW584966 * | MW584957 * | MW703370 * | MW645212 * | n.d. | MW727523 * | |
| MUT 1950 T | Oil-contaminated seawater | KU935664 | MW584972 * | MW584963 * | MW703376 * | MW645217 * | MW666026 * | MW727529 * | |
| MUT 1954 | Oil-contaminated seawater | KU935659 | MW584973 * | MW584964 * | MW703377 * | MW645218 * | MW666027 * | MW727530 * | |
| MUT 1961 | Oil-contaminated seawater | KU935662 | MW584974 * | MW584965 * | MW703378 * | MW645219 * | MW666028 * | MW727531 * | |
| MUT 5040 | P. oceanica | MW582549 * | MW584967 * | MW584958 * | MW703371 * | MW645213 * | MW666022 * | MW727524 * | |
| MUT 5048 | P. oceanica | MW582550 * | MW584968 * | MW584959 * | MW703372 * | MW645214 * | MW666023 * | MW727525 * | |
| MUT 5049 | P. oceanica | MW582551 * | MW584969 * | MW584960 * | MW703373 * | n.d. | n.d. | MW727526 * | |
| MUT 5082 | P. oceanica | MW582552 * | MW584970 * | MW584961 * | MW703374 * | MW645215 * | MW666024 * | MW727527 * | |
| C. pseudopulchella | NBRC 32113 | Seafoam | -- | JN941651 | JN941495 | -- | JN992383 | -- | -- |
| NBRC 32112 T | Seafoam | -- | JN941652 | JN941494 | -- | JN992384 | -- | -- | |
| C. pulchella | NBRC 32123 | Beach sand | JN943446 | JN941650 | JN941496 | -- | JN992382 | -- | -- |
| NBRC 32124 | Beach sand | -- | JN941649 | JN941497 | -- | JN992381 | -- | -- | |
| C. quinqueseptata | NBRC 32114 T | Sea foam | -- | JN941648 | JN941498 | -- | JN992380 | -- | -- |
| NBRC 32115 | Sargassum sagamianum | -- | JN941647 | JN941499 | -- | JN992379 | -- | -- | |
| Magnisphaera stevemossago | CBS 139776 | -- | KT278691 | KT278704 | -- | -- | KT278740 | -- | |
| Natantispora unipolaris | NTOU3741 | KM624523 | KM624521 | KM624522 | -- | -- | -- | -- | |
| Pileomyces formosanus | BBH30192 | JX003862 | KX686803 | KX686804 | -- | -- | -- | -- | |
| Remispora maritima | BBH28309 | -- | HQ111002 | HQ111012 | -- | -- | -- | -- | |
| Tinhaudeus formosanus | NTOU3805 | KT159895 | KT159897 | KT159899 | -- | -- | -- | -- | |
| Microascaceae | -- | -- | -- | -- | -- | -- | -- | ||
| Cephalotrichum stemonitis | AFTOL-ID 1380 | n.d | -- | DQ836901 | DQ836907 | DQ836916 | -- | -- | -- |
| Microascus trigonosporus | AFTOL-ID 914 | n.d | DQ491513 | DQ471006 | DQ470958 | DQ471077 | DQ471150 | DQ470908 | -- |
| Petriella setifera | CBS 437.75 | Driftwood | -- | DQ471020 | DQ470969 | -- | DQ842034 | DQ836883 | -- |
| Forward and Reverse Primers | Thermocycler Conditions | References | |
|---|---|---|---|
| ITS | ITS1-ITS4 | 95 °C: 5 min, (95 °C: 40 s, 55 °C: 50 s, 72 °C: 50 s) × 35 cycles; 72 °C: 8 min; 4 °C: ∞ | [35] |
| LSU | LR0R-LR7 | 95 °C: 5 min, (95 °C: 1 min, 50 °C: 1 min, 72 °C: 2 min) × 35 cycles; 72 °C: 10 min; 4 °C: ∞ | [36] |
| SSU | NS1-NS4 | 95 °C: 5 min, (95 °C: 1 min, 50 °C: 1 min, 72 °C: 2 min) × 35 cycles; 72 °C: 10 min; 4 °C: ∞ | [35] |
| TEF-1α | EF-dF/EF-2218R | 95 °C: 5 min, (95 °C: 1 min, 50 °C: 1 min; 72 °C: 2 min) × 40 cycles, 72 °C: 10 min; 4 °C: ∞ | [37] |
| βTUB | Bt2a-Bt2b | 94 °C: 4 min, (94 °C: 35 sec, 58 °C: 35 s, 72 °C: 50 s) × 35 cycles; 72 °C: 5 min; 4 °C: ∞ | [38] |
| RPB1 | RPB1Af-RPB1Cr | 96 °C: 5 min, (94 °C: 30 s, 52 °C: 30 s, 72 °C: 1 min) × 40 cycles; 72 °C: 8 min; 4 °C: ∞ | [39] |
| RPB2 | fRPB2-5F/fPB2-7cR | 94 °C: 3 min, (94 °C: 30 s; 55 °C: 30 s; 72 °C: 1 min) × 40 cycles, 72 °C: 10 min; 4 °C: ∞ | [40] |
Publisher’s Note: MDPI stays neutral with regard to jurisdictional claims in published maps and institutional affiliations. |
© 2021 by the authors. Licensee MDPI, Basel, Switzerland. This article is an open access article distributed under the terms and conditions of the Creative Commons Attribution (CC BY) license (https://creativecommons.org/licenses/by/4.0/).
Share and Cite
Poli, A.; Bovio, E.; Perugini, I.; Varese, G.C.; Prigione, V. Corollospora mediterranea: A Novel Species Complex in the Mediterranean Sea. Appl. Sci. 2021, 11, 5452. https://doi.org/10.3390/app11125452
Poli A, Bovio E, Perugini I, Varese GC, Prigione V. Corollospora mediterranea: A Novel Species Complex in the Mediterranean Sea. Applied Sciences. 2021; 11(12):5452. https://doi.org/10.3390/app11125452
Chicago/Turabian StylePoli, Anna, Elena Bovio, Iolanda Perugini, Giovanna Cristina Varese, and Valeria Prigione. 2021. "Corollospora mediterranea: A Novel Species Complex in the Mediterranean Sea" Applied Sciences 11, no. 12: 5452. https://doi.org/10.3390/app11125452
APA StylePoli, A., Bovio, E., Perugini, I., Varese, G. C., & Prigione, V. (2021). Corollospora mediterranea: A Novel Species Complex in the Mediterranean Sea. Applied Sciences, 11(12), 5452. https://doi.org/10.3390/app11125452

